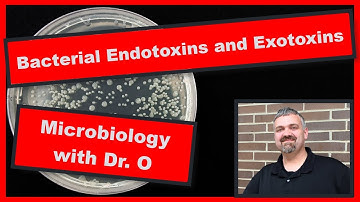
Bacterial Endotoxins and Exotoxins:  Microbiology

⬇ DOWNLOAD NOW
Kalau muncul iklan pop-up, tutup lalu klik tombol kembali
Download lagu Overview of Toxins | Exotoxins Vs Endotoxins secara gratis hanya untuk keperluan promosi. Dukung artis favorit kamu dengan membeli musik original di iTunes atau platform resmi lainnya.
 Exotoxins vs. Endotoxins - Microbiology 🧫 & Infectious Diseases 🦠
Exotoxins vs. Endotoxins - Microbiology 🧫 & Infectious Diseases 🦠
 Endotoxins vs. Exotoxins
Endotoxins vs. Exotoxins
 Bacterial Toxin | Exotoxin | Endotoxin | Microbiology | Basic Science Series
Bacterial Toxin | Exotoxin | Endotoxin | Microbiology | Basic Science Series
 Overview of toxins | Exotoxins vs Endotoxins | Differences between Exotoxins & Endotoxins |
Overview of toxins | Exotoxins vs Endotoxins | Differences between Exotoxins & Endotoxins |
Bacterial Endotoxins and Exotoxins: Microbiology
Bacterial Endotoxins and Exotoxins: Microbiology
 bacterial toxins: Endotoxin and Exotoxins
bacterial toxins: Endotoxin and Exotoxins
 1 minute learning: Exotoxin Versus Endotoxin
1 minute learning: Exotoxin Versus Endotoxin
 Endotoxins and Exotoxins
Endotoxins and Exotoxins